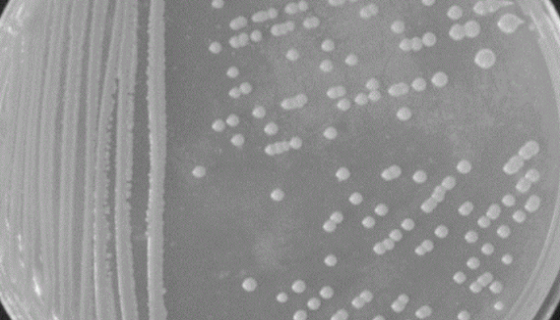
ATCC 14929 烟草节杆菌的特征特性及培养方法！

马杜拉放线菌——代谢产物具有抗真菌活性
马杜拉放线菌是Actinomadura属的微生物,原产地为中...

T24人膀胱移行细胞癌细胞的培养与传代及应用!
T24人膀胱移行细胞癌细胞源自一位81岁白人女性患者的膀胱移...
ATCC 14929 烟草节杆菌的特征特性及培养方法!
烟草节杆菌是中国农业科学网收藏的一种非模式菌株。主要用于教学...

山羊外周血单核细胞复苏与传代及冻存操作说明!
山羊外周血单核细胞取自雄性个体,悬浮培养。仅用于科学研究或者...

ATCC 19420耻垢分枝杆菌的特点与优势及培养!
耻垢分枝杆菌,英文名称为mycolicibacterium...

NCM460人正常结肠上皮细胞的处理方法与培养步骤!
人正常结肠上皮细胞接收后的处理方法与培养步骤!

恰塔努链霉菌的培养方法与实验内容及使用范围!
恰塔努链霉菌,孢子丝圈卷至螺旋形,有时柔曲。孢子球形、椭圆形...

HSKMC人骨骼肌细胞接收后的处理与培养方法!
人骨骼肌细胞接收后的处理与培养方法及注意事项有哪些?

ATCC 8158 排硫硫杆菌 百欧博伟生物
排硫硫杆菌Thio6acillus thiaparus 硫杆...